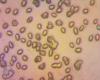
g_t1.jpg
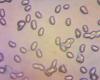
gi_t1.jpg
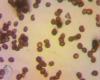
melkoe1_t1.jpg

|
|
|
|
84

Гигроцибе
Дата: 11.07.11
Добавлено: Tonya
Комментариев: 0
Просмотров: 1240
|
|
86

головач
Дата: 11.07.11
Добавлено: Tonya
Комментариев: 0
Просмотров: 1290
|
87

коричневое
Дата: 11.07.11
Добавлено: Tonya
Комментариев: 0
Просмотров: 1157
|
|
|
|
|
|
|
|
|
|
|
|
|
|
|
|
|
|
|
|
|
|
|
|
|
|
|
|
|
|
|
|
114

0206082011
Дата: 17.08.11
Добавлено: Tonya
Комментариев: 0
Просмотров: 1197
|
115

0206082011
Дата: 17.08.11
Добавлено: Tonya
Комментариев: 0
Просмотров: 1307
|
|
|
|
|
119

Валуй
Дата: 09.01.13
Добавлено: Tonya
Комментариев: 0
Просмотров: 1403
|
120

0606082011
Дата: 17.08.11
Добавлено: Tonya
Комментариев: 0
Просмотров: 1284
|
















































 грибы
грибы фотогалерея
фотогалерея флора
флора фауна
фауна птицы
птицы млекопитающие
млекопитающие пресмыкающиеся
пресмыкающиеся земноводные
земноводные бабочки
бабочки насекомые
насекомые рыбы
рыбы видео
видео казахстан
казахстан кулинария
кулинария статьи
статьи ссылки
ссылки о нас
о нас